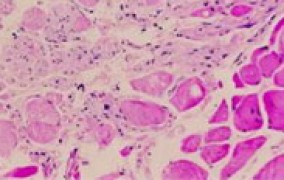

Busca - 39387 notícias encontradas
-
Caracterização de Proteínas por Dicroísmo Circular e Espalhamento Dinâmico de Luz
14 de junho de 2011Curso na Unesp em Botucatu tem por objetivo a capacitação dos participantes para a caracterização de amostras proteicas em solução: -
Curso de Tecnologia Pós-Colheita de Frutas e Hortaliças
14 de junho de 2011Evento em São Carlos, promovido pela Embrapa, visa à aplicação de tecnologias que minimizem perdas e possibilitem a aplicação de melhorias no setor -
Clima e doenças emergentes
13 de junho de 2011Projeto Temático do Programa FAPESP de Pesquisa sobre Mudanças Climáticas Globais investiga relação entre transformações socioambientais na Amazônia e alterações na abrangência geográfica de doenças infecciosas -
Fonte de novos medicamentos
13 de junho de 2011Indústrias farmacêuticas enfrentam crise de criatividade para desenvolver moléculas bioativas inovadoras e recorrem às universidades, dizem cientistas -
CNPq premia destaques na iniciação científica
13 de junho de 2011Prêmio em parceria com ABC e SBPC tem inscrições abertas até 19 de agosto. Três primeiros colocados de cada área receberão, respectivamente, R$ 5,1 mil, R$ 4,2 e R$ 3,3 mil -
5º Congresso Interdisciplinar de Dor
13 de junho de 2011Encontro no Hospital das Clínicas da FMUSP tem por objetivo discutir os avanços na avaliação e no tratamento em dor aguda e crônica -
Four Biotec – Quatro dias pela Biotecnologia
13 de junho de 2011Encontro na UFSCar abordará aplicações da biotecnologia em diversas áreas -
Escudo contra a superinfecção
10 de junho de 2011Graças à restrição de ferro causada no fígado do hospedeiro, a própria infecção pelo parasita da malária previne a ocorrência de uma segunda infecção, mais severa, indica estudo publicado na Nature Medicine com participação brasileira -
Paulo Alexandre Barbosa visita a FAPESP
10 de junho de 2011Secretário de Desenvolvimento Econômico, Ciência e Tecnologia do Estado de São Paulo se reúne com os membros do Conselho Superior da FAPESP -
Ciência brasileira em luto
10 de junho de 2011Morrem os professores e pesquisadores Juarez Rubens Brandão Lopes (esq.), Patricio Aníbal Letelier Sotomayor e Henrique Rattner (dir.) -
Unesp de Bauru lança revista
10 de junho de 2011Publicação da Faculdade de Arquitetura, Artes e Comunicação, voltada para a comunidade acadêmica, abrange diversas áreas do conhecimento -
Unibral e Probral recebem projetos até 30 de junho
10 de junho de 2011Programas de parcerias universitárias entre o Brasil e a Alemanha e de projetos conjuntos de pesquisadores dos dois países são conduzidos pelo DAAD -
Simpósio de Pós-graduação em Análises Clínicas
10 de junho de 2011Culturas celulares e suas aplicações na cadeia farmacêutica é um dos temas que serão abordados durante o evento, promovido pela USP -
Fórum de Ciência e Tecnologia Multimídia no ensino presencial
10 de junho de 2011Objetivo do evento, realizado pela Unicamp, é promover a reflexão sobre o potencial das tecnologias no ensino -
Refúgios ameaçados
09 de junho de 2011Diminuição das APPs e da reserva legal, proposta pelo projeto de reforma do Código Florestal, pode colocar em risco espécies que dependem dos fragmentos florestais, alertam pesquisadores do programa BIOTA-FAPESP em carta publicada na Science -
Curso de empreendedorismo nos Estados Unidos
09 de junho de 2011Unicamp seleciona aluno para realizar curso intensivo no Babson College, com duração de duas semanas e início em 25 de julho -
ICMC-USP recebe finais da OBI
09 de junho de 2011Encerramento da 13ª Olimpíada Brasileira de Informática, que selecionará participantes para a Olimpíada Internacional na Tailândia, será em São Carlos -
The Future of Global Governance - Brazil in the Global Climate Change Regime
09 de junho de 2011Workshop, que será realizado em São Paulo, é promovido pelo Instituto de Relações Internacionais (IRI) da USP e pela Escola Balsillie de Relações Internacionais, da Universidade de Waterloo (Canadá) -
3º Seminário Inovações Curriculares
09 de junho de 2011Evento promovido pela Unicamp promoverá troca de experiências em inovação curricular entre docentes de universidades paulistas -
Proteção bacteriana
08 de junho de 2011Estudo publicado na Science, com participação brasileira, mostra como plantas exploram combinação específica de bactérias do solo para se proteger de patógenos. Trabalho identificou 33 mil microrganismos -
São Paulo terá núcleo de pesquisa em bioenergia e sustentabilidade
08 de junho de 2011Iniciativa, anunciada durante a comemoração dos 110 anos da Esalq, reunirá pesquisadores e acadêmicos da USP, Unicamp e Unesp para realizar pesquisas e formar especialistas com foco na energia de biomassa -
PD em engenharia de biossistemas com Bolsa da FAPESP
08 de junho de 2011Projeto apoiado pelo Instituto Microsoft Research-FAPESP de Pesquisas em TI tem vaga para pós-doutoramento -
Publicações acadêmicas da Unesp em acervo digital
08 de junho de 2011Ferramenta com mais de 25 mil itens educacionais tem acesso gratuito -
Schizophrenia International Research Society Conference América do Sul
08 de junho de 2011Evento em São Paulo, promovido pela International Society Schizophrenia Research, tem o objetivo de discutir estratégias para o desenvolvimento de novos tratamentos para a doença mental -
12º Simpósio de Controle Biológico (Siconbiol 2011)
08 de junho de 2011O uso de agentes de controle biológico de pragas será debatido no evento realizado pelo Instituto Biológico -
FAPESP e MIT lançam nova chamada
07 de junho de 2011Seleção apoiará propostas de intercâmbio de pesquisadores de instituições no Estado de São Paulo e do Instituto de Tecnologia de Massachusetts, nos Estados Unidos -
Novo centro de pesquisa em física
07 de junho de 2011Unesp sediará primeira unidade na América do Sul do Centro Internacional de Física Teórica, vinculado à Unesco. Atividades deverão começar em 2012 -
Energia a partir de palha de cana livre de ICMS
07 de junho de 2011Decreto assinado pelo governador de São Paulo, Geraldo Alckmin, representa incentivo a projetos de produção de energia limpa no setor sucroalcooleiro -
Pós-graduação em toxinologia no Butantan
07 de junho de 2011Instituto oferece 12 vagas para mestrado e doutorado direto e oito para doutorado. Inscrições ocorrem entre 13 e 17 de junho -
3º Ciclo de Atualização em Biologia e Controle de Animais Sinantrópicos de Importância em Saúde Pública
07 de junho de 2011Encontro na FSP-USP terá a palestra “Fauna Necrófila: Forídeos”, com o professor Adelino Poli Neto
Mais lidas do mês
-
Pesquisadoras descobrem nova espécie de microrganismo adaptado a frio e calor extremos na Antártida
01 de junho de 2026
-
Combinação de metais abundantes pode baratear produção de hidrogênio verde
02 de junho de 2026
-
Parceria científica entre Brasil e Argentina resiste a crises e fragmentação geopolítica
02 de junho de 2026
-
Relógio inteligente detecta ansiedade e estresse em tempo real
08 de junho de 2026
-
Brasil precisa superar gargalos ambientais e tecnológicos para viabilizar mineração de terras-raras
03 de junho de 2026
-
Novo modelo físico explica rotação retrógrada de Vênus como resultado natural da evolução planetária
01 de junho de 2026
-
Nanotecnologia brasileira permite tratar doenças de pele com precisão
03 de junho de 2026
-
FAPESP busca impulsionar colaboração científica entre São Paulo e o Reino Unido
01 de junho de 2026
-
FAPESP e Reino Unido abrem nova fase de cooperação científica em Londres
03 de junho de 2026
-
Inteligência artificial converte câmeras de segurança em sistemas de monitoramento ativo
02 de junho de 2026